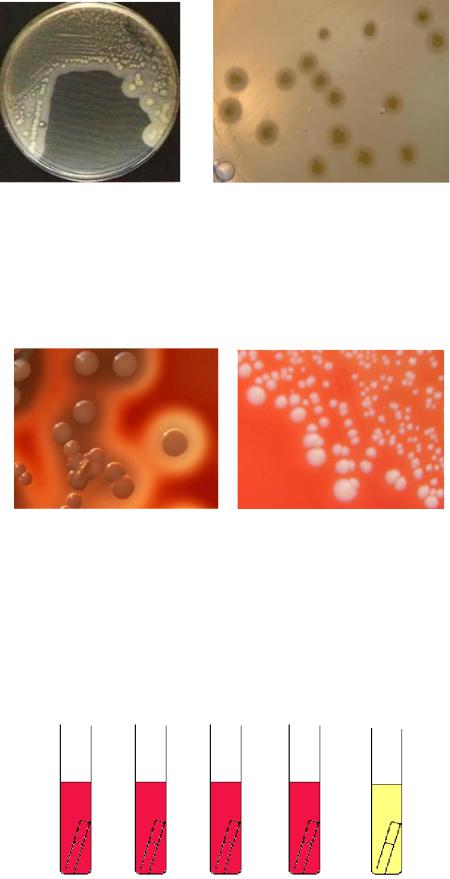

Материал: Грамположительные аэробные Кокки

6
Среди стафилококков выделяют патогенные виды (в частности, S. aureus), условно-патогенные виды (например, S. epidermidis) и непатогенные виды (в
частности, S. saprophyticus).
С точки зрения патогенетических признаков важной является классификация стафилококков по способности продуцировать плазмокоагулазу. По этому признаку стафилококки подразделяются на коагулазоположительные или коагулазопозитивные (к ним относится золотистый стафилококк – S. aureus) и
коагулазоотрицательные или коагулазонегативные стафилококки (к ним относятся эпидермальный и сапрофитный стафилококки – S. epidermidis и S. saprophyticus). Внутри вида по чувствительности к бактериофагам S. aureus подразделяется на фагогруппы и фаговары.
Морфологические и тинкториальные свойства стафилококков.
Стафилококки имеют шаровидную форму, диаметр клеток составляет 0,5-1,5 мкм. В мазках из культур, выросших на питательных средах, они образуют скопления, напоминающие виноградные грозди. Такое расположение обусловлено делением клеток в разных плоскостях (рисунок 4).
Рисунок 4 – Схема образования виноградной грозди при делении стафилококков (красные линии показывают расположение плоскостей, в которых происходит деление отдельных клеток).
В патологическом материале стафилококки располагаются небольшими группами (рисунок 5).
а б Рисунок 5 – Стафилококки. Компьютерная визуализация (а) и сканирующая
электронная микроскопия (б).
Стафилококки неподвижны, спор не образуют. Некоторые стафилококки могут образовывать микрокапсулу. По Граму стафилококки окрашиваются положительно (рисунок 6).

7
Капсула
а б Рисунок 6 – Стафилококки. Просвечивающая электронная микроскопия (а) и
иммерсионная микроскопия, окраска по Граму (б).
Культуральные и биохимические свойства стафилококков.
Стафилококки являются факультативными анаэробами, хорошо растут в аэробных условиях при температуре 35-40ОС и рН 7,0-7,5 на простых питательных средах (на мясо-пептонном агаре – МПА и в мясо-пептонном бульоне - МПБ). На МПА стафилококки образуют ровные круглые колонии S-формы диаметром 2-4 мм, которые могут быть окрашены в желтый, белый, оранжевый, кремовый цвета. Цвет колоний обусловлен наличием пигмента, синтезируемого стафилококками в аэробных условиях. Однако пигментообразование не является видовым признаком стафилококков. При размножении в жидких питательных средах стафилококки вызывают равномерное помутнение (рисунок 7).
а б в Рисунок 7 – Колонии стафилококков на МПА (а), внешний вид колоний золотистого
стафилококка на МПА (б) и характер роста стафилококков в МПБ (в).
Стафилококки являются представителями галофильных (солеустойчивых) бактерий: они хорошо растут при высоких концентрациях в питательной среде хлорида натрия (10-15%). Поэтому элективными для стафилококков являются питательные среды с повышенным содержанием NaCl: желточно-солевой агар (ЖСА), молочно-солевой агар (МСА), молочно-желточно-солевой агар (МЖСА). На желточно-солевом агаре патогенные стафилококки формируют колонии, окруженные радужным венчиком за счет разложения лецитина яичного желтка с помощью фермента лецитиназы (рисунок 8).
8
а б Рисунок 8 – Характер роста стафилококков на желточно-солевом агаре (а) и зоны
опалесценции вокруг колоний (б).
На кровяном агаре золотистый стафилококк формирует колонии, окруженные зоной гемолиза, эпидермальный стафилококк зон гемолиза не образует (рисунок 9).
а б Рисунок 9 – Характер роста на кровяном агаре золотистого стафилококка (а) и
эпидермального стафилококка (б).
Стафилококки обладают высокой биохимической активностью: они ферментируют в аэробных условиях многие углеводы до уксусной кислоты без газа. В частности, S. aureus разлагает до кислоты глюкозу, сахарозу, лактозу, маннит и не ферментирует мальтозу (рисунок 10).
Глюкоза Сахароза Лактоза Маннит Мальтоза
Рисунок 10 – Ферментация углеводов золотистым стафилококком.
Разные виды стафилококков ферментируют разный спектр углеводов. Дифференциально-диагностическое значение имеет тест на сбраживание глюкозы в

9
анаэробных условиях. Ферментация глюкозы в анаэробных условиях с образованием молочной кислоты характерна для стафилококков и отличает их от стрептококков. Для проведения этого теста используют готовую среду с индикатором ВР (водорастворимым голубым) или среду Хью-Лейфсона с индикатором бромтимоловым синим. Исходная среда имеет лиловый (среда с индикатором ВР) или зеленый (среда Хью-Лейфсона) цвет. Аэробные бактерии окисляют глюкозу, то есть образуют кислоту только в среде без вазелинового масла. Анаэробные бактерии ферментируют глюкозу, то есть образуют кислоту только в среде с вазелиновым маслом. Факультативные анаэробы, к которым относится золотистый стафилококк, утилизируют глюкозу в аэробных и анаэробных условиях. Посев осуществляют уколом в столбик питательной среды в две пробирки. После посева для создания анаэробных условий среду в одной из пробирок заливают слоем стерильного вазелинового масла. Культивирование проводят в течение 3-4 суток. Образование кислоты приводит к желтому окрашиванию столбика среды (рисунок
11).
а б Рисунок 11 – Окисление глюкозы аэробными бактериями (а) и сбраживание
глюкозы факультативными анаэробами (б).
Стафилококки разжижают желатин в виде воронки, белки расщепляют до аммиака и сероводорода, не образуют индола.
Патогенные виды стафилококков (в частности, S. aureus) продуцируют плазмокоагулазу (коагулазоположительные) и фибринолизин. S. epidermidis и S. saprophyticus не продуцируют плазмокоагулазу (коагулазоотрицательные). Плазмокоагулазу и фибринолизин выявляют следующим образом. В пробирку с плазмой крови кролика вносят исследуемую культуру и инкубируют в течение суток при температуре 36ОС. При положительной реакции образуется плотный сгусток. Для выявления фибринолитической активности пробирку со сгустком оставляют в термостате еще на сутки. При наличии фибринолизина сгусток разжижается (рисунок 12). В последние годы в материале от больных все чаще обнаруживают коагулазоотрицательные стафилококки, считавшиеся ранее непатогенными бактериями.

10
Рисунок 12 – Свертывание плазмы коагулазой (верхняя пробирка) и разжижение сгустка фибринолизином (нижняя пробирка).
Стафилококки продуцируют каталазу (каталазоположительные), что отличает их от стрептококков и энтерококков, которые являются каталазоотрицательными бактериями. Каталаза разрушает перекись водорода, в результате чего стафилококки защищены от высокотоксичных производных кислорода. Продуцирование каталазы выявляется при добавлении к микробной культуре (на плотной питательной среде или на стекле) 1% раствора перекиси водорода. Положительная реакция проявляется выделением пузырьков газа (рисунок 13).
а б Рисунок 13 – Выявление каталазы стафилококков с помощью перекиси водорода на
питательном агаре (а) и на стекле (б).
Стафилококки являются оксидазоотрицательными, то есть не продуцируют оксидазу. Например, цитохромоксидазу выявляют путем нанесения капли суточной микробной культуры на фильтровальную бумажку, смоченную специальным реактивом (1% спиртовый раствор α-нафтола; 1% водный раствор N-диметил-β- фенилендиамина дигидрохлорида). В положительном случае на месте нанесения культуры появляется синее окрашивание. Для постановки этого теста выпускаются специальные слайды (рисунок 14).